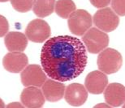
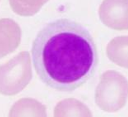
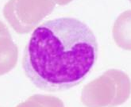

Which cocci are gram positive and which are negative?
Which basili are gram positive and which are negative?
Most cocci are gram positive EXCEPT
Most bacili gram negative EXCEPT
What cell type is this?
Eosinophil
What cell type is this?

Basophil
What cell type is this?
Lymphocyte
What cell type is this?

Neutrophil
What cell type is this?
Monocyte
Which of the following vaccines is least likely to induce long term immunologic memory?
A) Bacille Calmette-Guérin (BCG).
B) Diphtheria-tetanus-pertussis.
C) Haemophilus influenzae type B conjugate.
D) Hepatitis B.
E) Pneumococcal polysaccharide.
Pneumococcal polysaccharide
Pneumococcal polysaccharide vaccine is available for children aged 2 years and older as younger children are unable to mount an appropriate immune response to the non-conjugated vaccine (or actual pneumococcal disease).
Most healthy older people respond well to the vaccine, but those in groups at high risk of invasive pneumococcal disease may exhibit a poor immune response. It is unclear how long the antibody response lasts and most people will require a second vaccination after 3-5 years depending on age.
High risk children less than 5 years of age would generally be given both the polysaccharide and the conjugated vaccine for maximum protection.
What organism is most likely to cause purulent otitis media?
Strep Pneumoniae
MOA aminoglycosides
Aminoglycasides - binding to the 30S ribosomal subunit – bacteriocidal to Gram Negatives – peak concentration killing.
MOA macrolides
Macrolides - bind to the 50S subunit of bacterial ribosomes – Resistance (i) alteration in ribosomal proteins (ii) macrolide efflux pump
MOA Quinolones
Quinolones - direct inhibitors of bacterial DNA synthesis (Fluoroquinolones inhibit DNA gyrases). Resistance - mutation in chromosomal genes
MOA tetracyclines
Tetracyclines – binds 30S ribosomal subunit - bacteriostatic effect.
MOA Vancomycin
Vancomycin - Inhibits bacterial cell wall synthesis by blocking glycopeptide polymerization – VRE Vancomycin resistance gene cluster – ALTERS vanc binding site to low affinity site.
MOA Trimethoprim-sulfamethoxazole
Trimethoprim-sulfamethoxazole: Folate synthesis inhibition (Reduced availability of THF inhibits thymidine synthesis and subsequently DNA synthesis) Resitance – decreased perm and efflux.
MOA Linezolid
Linezolid: Inhibits bacterial protein synthesis by binding to bacterial 23S ribosomal RNA of the 50S subunit.
MOA Penicillins/Beta lactams
Penicillins/Beta Lactams – inactivating enzymes located in the bacterial cell membrane, which are involved in the third stage of cell wall synthesis.
Enzymes = penicillin binding proteins (PBPs).
Bactericidal by autolytic enzymes.
Resistance:
Carbapenems (ß-lactam, ie meropenem) – resist beta-lactamases; Beta-Lactamase Inhibitors